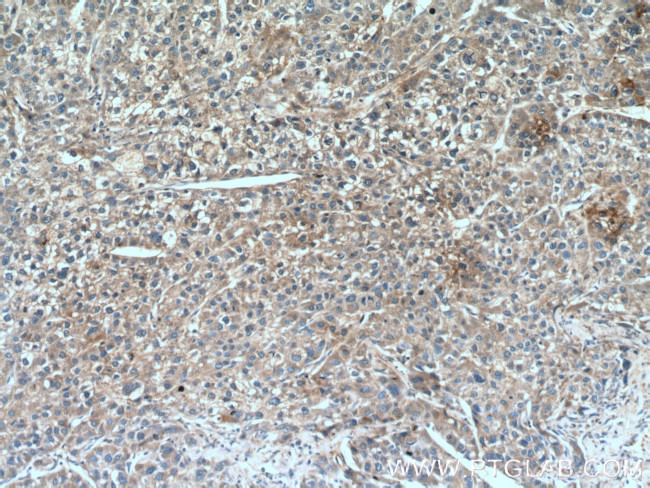
TSSK3 Antibody in Immunohistochemistry (Paraffin) (IHC (P))

Search
Proteintech
TSSK3 Polyclonal Antibody
{{$productOrderCtrl.translations['antibody.pdp.commerceCard.promotion.promotions']}}
{{$productOrderCtrl.translations['antibody.pdp.commerceCard.promotion.viewpromo']}}
{{$productOrderCtrl.translations['antibody.pdp.commerceCard.promotion.promocode']}}: {{promo.promoCode}} {{promo.promoTitle}} {{promo.promoDescription}}. {{$productOrderCtrl.translations['antibody.pdp.commerceCard.promotion.learnmore']}}
产品信息
12940-1-AP
种属反应
宿主/亚型
分类
类型
抗原
偶联物
形式
浓度
规格
纯化类型
保存液
内含物
保存条件
运输条件
产品详细信息
Immunogen sequence: MEDFLLSNG YQLGKTIGEG TYSKVKEAFS KKHQRKVAIK VIDKMGGPEE FIQRFLPREL QIVRTLDHKN IIQVYEMLES ADGKICLVME LAEGGDVFDC VLNGGPLPES RAKALFRQMV EAIRYCHGCG VAHRDLKCEN ALLQGFNLKL TDFGFAKVLP KSHRELSQTF CGSTAYAAPE VLQGIPHDSK KGDVWSMGVV LYVMLCASLP FDDTDIPKML WQQQKGVSFP THLSISADCQ DLLKRLLEPD MILRPSIEEV SWHPWLAST (1-268 aa encoded by BC035354 )
靶标信息
This gene encodes a kinase expressed exclusively in the testis that is thought to play a role in either germ cell differentiation or mature sperm function.
仅用于科研。不用于诊断过程。未经明确授权不得转售。
生物信息学
蛋白别名: serine/threonine kinase 22C; serine/threonine kinase 22C (spermiogenesis associated); Serine/threonine-protein kinase 22C; spermiogenesis associated; spermiogenesis associated 3; spermiogenesis associated serine/threonine kinase 22D; testis specific serine kinase-3; testis-specific kinase 3; testis-specific serine/threonine kinase 22C; testis-specific serine/threonine kinase 3b; Testis-specific serine/threonine-protein kinase 3; TSK-3; TSSK-3
基因别名: 1700014N07Rik; 4930594I21Rik; SPOGA3; STK22C; STK22D; Tsk-3; TSK3; Tssk-3; TSSK3; Tssk3b
UniProt ID: (Human) Q96PN8, (Mouse) Q9D2E1
Entrez Gene ID: (Human) 81629, (Mouse) 58864, (Rat) 297891